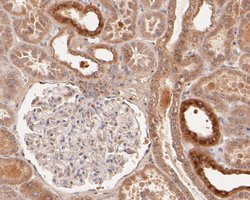
Invitrogen Syntrophin alpha-1 Polyclonal Antibody 100 &mu;L | Buy Online | Invitrogen&trade; | Fisher Scientific

missing translation for 'onlineSavingsMsg'
Learn More
Learn More
Description
Syntrophin alpha-1 Polyclonal Antibody for Western Blot, ICC/IF, IHC (P), Flow
Syntrophin alpha-1 (Dystrophin, SNTA1) is a large, rod-like cytoskeletal protein found at the inner surface of muscle fibers. Dystrophin is missing in Duchenne Muscular Dystrophy patients and is present in reduced amounts in Becker Muscular Dystrophy patients. The protein encoded by this gene is a peripheral membrane protein found associated with dystrophin and dystrophin-related proteins. This gene is a member of the syntrophin gene family, which contains at least two other structurally-related genes.

Specifications
Specifications
| Antigen | Syntrophin alpha-1 |
| Applications | Flow Cytometry, Immunohistochemistry (Paraffin), Western Blot, Immunocytochemistry |
| Classification | Polyclonal |
| Concentration | 1 mg/mL |
| Conjugate | Unconjugated |
| Formulation | PBS with 0.2% BSA, 50% glycerol and 0.05% sodium azide; pH 7.4 |
| Gene | SNTA1 |
| Gene Accession No. | Q13424, Q61234 |
| Gene Alias | 59 kDa dystrophin-associated protein A1 acidic component 1; 59-1 DAP; acidic alpha 1 syntrophin; alpha-1-syntrophin; alpha1-syntrophin; alpha-syntrophin; AW228934; dJ1187J4.5; dystrophin-associated protein A1, 59kDa, acidic component; LQT12; pro-TGF-alpha cytoplasmic domain-interacting protein 1; RP23-192L3.1; SNT1; SNTA1; syntrophin alpha 1; syntrophin, acidic 1; syntrophin, alpha 1; syntrophin, alpha 1 (dystrophin-associated protein A1, 59kDa, acidic component); syntrophin-1; TACIP1; Unknown (protein for MGC:142519) |
| Gene Symbols | SNTA1 |
| Show More |
Product Title
By clicking Submit, you acknowledge that you may be contacted by Fisher Scientific in regards to the feedback you have provided in this form. We will not share your information for any other purposes. All contact information provided shall also be maintained in accordance with our Privacy Policy.
Spot an opportunity for improvement?